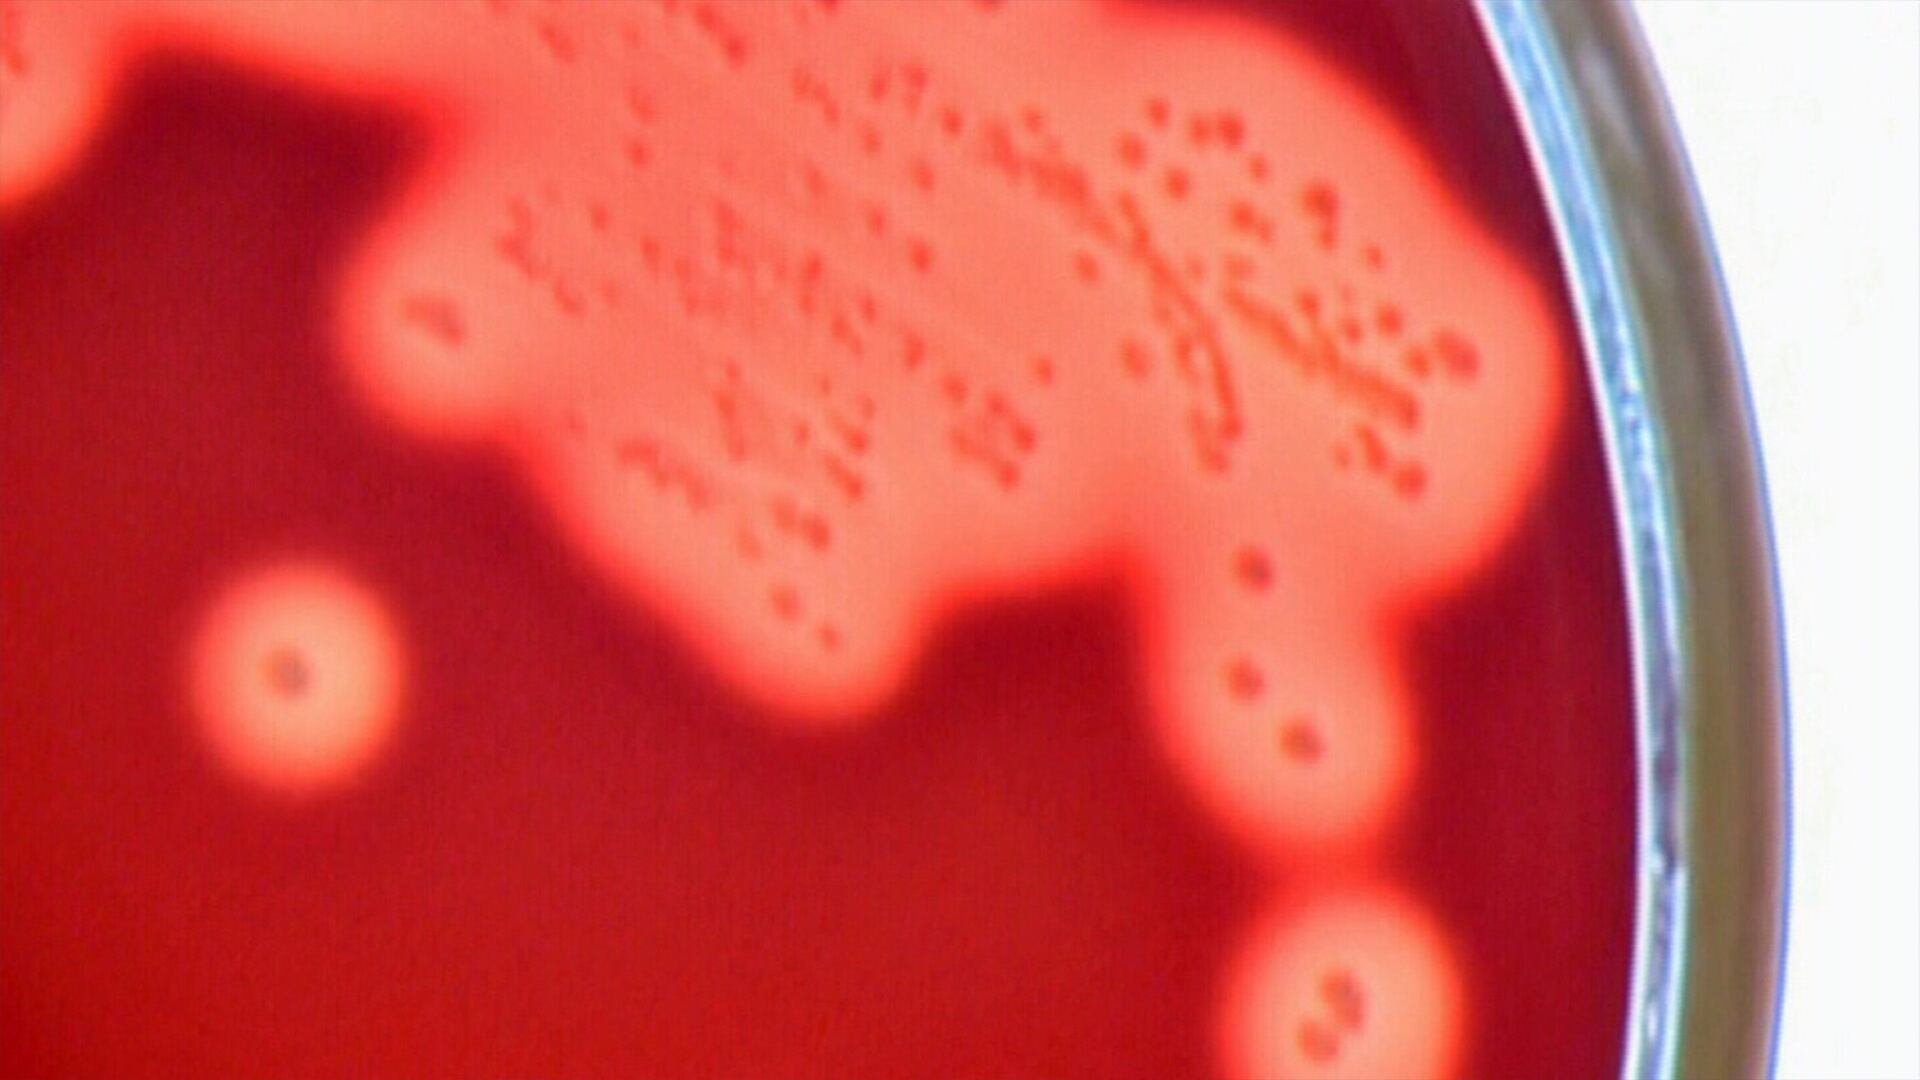

Des pays du monde entier signalent une augmentation soutenue du nombre d'infections invasives à streptocoques du groupe A (iSGA) à un moment où la saison des infections streptococciques devrait toucher à sa fin, et le Canada en fait partie.
Ce texte est une traduction d'un article de CTV News.
L'iSGA est une infection potentiellement mortelle impliquant la bactérie streptococcique du groupe A (SGA), normalement inoffensive. Alors que l'infection à SGA provoque souvent des maladies bénignes telles que l'amygdalite, l'angine streptococcique, la scarlatine et une infection cutanée appelée cellulite, l'iSGA peut provoquer une maladie grave et, dans de rares cas, la mort en quelques jours.
L'Ontario et le Québec ont signalé des taux d'infection par l'iSGA plus élevés au cours de la saison streptococcique d'automne et d'hiver 2022-2023 par rapport aux niveaux pré-pandémiques, et au Québec, les infections ont entraîné la mort de plusieurs enfants et personnes âgées.
L'Ontario a signalé 538 cas entre octobre 2022 et février 2023, et le Dr David Fisman, médecin épidémiologiste et professeur d'épidémiologie à l'Université de Toronto, affirme que certains de ces cas ont été particulièrement graves.
«Il s'agit d'une infection rare, mais lorsqu'elle se produit, elle peut être dévastatrice», a expliqué le Dr Fisman à CTVNews.ca dans un courriel mercredi. «Depuis l'émergence d'Omicron, nous avons constaté une augmentation des iSGA dans les données de surveillance, et beaucoup d'entre nous qui travaillent en clinique ont vu des iSGA étrangement graves.»
À lire également: Ces bactéries qui nous mangent la chair
Selon l'Organisation mondiale de la santé, des pays comme la France, l'Irlande, les Pays-Bas, la Suède, le Royaume-Uni et les États-Unis ont également signalé des pics prolongés de cas d'iSGA. Au Royaume-Uni, 355 personnes de tous âges sont décédées des suites d'infections cette saison.
Qu'est-ce que le SGA?
Le SGA est une bactérie commune qui ne peut survivre que sur et à l'intérieur des humains, explique John McCormick, professeur de microbiologie et d'immunologie à l'Université de Western Ontario.
«C'est la même bactérie que beaucoup d'enfants transportent de façon asymptomatique dans leur gorge sans montrer aucun signe de maladie.»
Certaines personnes porteuses de SGA ne présentent aucun symptôme, tandis que d'autres tomberont malades avec des symptômes tels que mal de gorge, fièvre, maux de tête et douleurs abdominales, mais se rétabliront d'elles-mêmes ou avec l'aide d'un antibiotique. Ces types de symptômes surviennent lorsque la bactérie est présente dans une partie du corps qui n'est pas considérée comme stérile, comme la gorge ou la surface de la peau. Il est courant que ces parties du corps soient exposées à des bactéries.
«Donc, une fois que vous trouvez (des bactéries) dans un endroit qui devrait être stérile, c'est alors qu'ils l'appellent invasif. Et celui-ci en particulier, quand il le fait, peut devenir très dangereux», a déclaré le professeur McCormick.
«S'il pénètre dans votre sang, par exemple, ou s'il pénètre dans les tissus mous, ou même dans vos muscles — c'est une fasciite nécrosante ou une myosite nécrosante — c'est très rare, mais cela arrive et cela peut être très dangereux.»
La fasciite nécrosante est également connue sous le nom de bactérie mangeuse de chair.
Selon la Dre Anna Banerji, spécialiste des maladies infectieuses pédiatriques, des maladies tropicales et de la santé mondiale à l'Université de Toronto, un patient qui survit à l'iSGA pourrait également faire face à des problèmes de santé à long terme.
«Il peut y avoir des complications post-streptococciques qui peuvent affecter les reins et affecter le cœur», a ajouté la Dre Banerji.
Pourquoi les chiffres augmentent-ils?
Selon la Dre Banerji, ce n'est probablement pas une coïncidence que les infections iGAS ont augmenté - ainsi que les virus respiratoires comme le VRS - après que de nombreux pays ont levé les restrictions de santé publique mises en place pour COVID-19.
«Cette dernière année a été une très mauvaise saison respiratoire, donc le streptocoque A peut être transporté dans la gorge et ne pas avoir beaucoup de symptômes, mais quand vous avez un rhume, cela permet au streptocoque d'envahir la place», a-t-elle dit.
La Dre Banerji explique que comme pour le RSV, de nombreux enfants ont évité l'exposition au streptocoque au plus fort de la pandémie et n'auraient pas les anticorps nécessaires pour combattre une infection maintenant.
Le professeur McCormick a déclaré qu'il existe une autre théorie populaire impliquant une poignée de souches mutantes de streptocoque A, dont une nommée M1UK. M1UK a été découvert pour la première fois au Royaume-Uni en 2019 et a été associé à des pics de scarlatine et d'iGAS.
«Il contient une mutation qui signifie qu'il produit beaucoup de toxine et cette toxine, nous le savons, pourrait être impliquée dans le syndrome de choc toxique streptococcique, qui est une forme très dangereuse de la maladie invasive.»
M. McCormick ne sait pas si M1UK ou toute autre souche mutante de SGA a été liée à l'un des cas d'iSGA signalés au Canada cette année, mais il sait que certaines des souches ont fait leur chemin jusqu'ici. Il a des échantillons dans son labo.
«Nous savons qu'ils sont au Canada et aux États-Unis et dans d'autres parties de l'Europe, et cela contribue donc probablement à l'augmentation», affirme-t-il.
Qu'est-ce que cela signifie pour les Canadiens?
Le taux d'infections à l'iSGA au Canada est en hausse depuis 2000, mais les infections demeurent rares, touchant généralement moins de 10 personnes sur 100 000.
«Je ne pense pas que les gens devraient être super inquiets, mais je pense qu'ils devraient être conscients de certains des symptômes», a analysé le professeur McCormick.
Parce que le SGA est si courant et que de nombreux porteurs sont asymptomatiques, McCormick a déclaré qu'il était difficile d'éviter l'exposition. Outre les pratiques exemplaires habituelles en matière de santé publique – comme pratiquer une bonne hygiène des mains, couvrir la toux et les éternuements et rester à la maison lorsque vous êtes malade – les Canadiens devraient savoir qu'ils doivent intervenir tôt lorsque des signes d'infection streptococcique apparaissent.
«S'ils ont un enfant avec un mal de gorge sévère ou de la fièvre et peut-être une éruption cutanée, alors ils devraient consulter leur médecin de famille et on leur prescrira probablement un antibiotique»,a-t-il conclut.